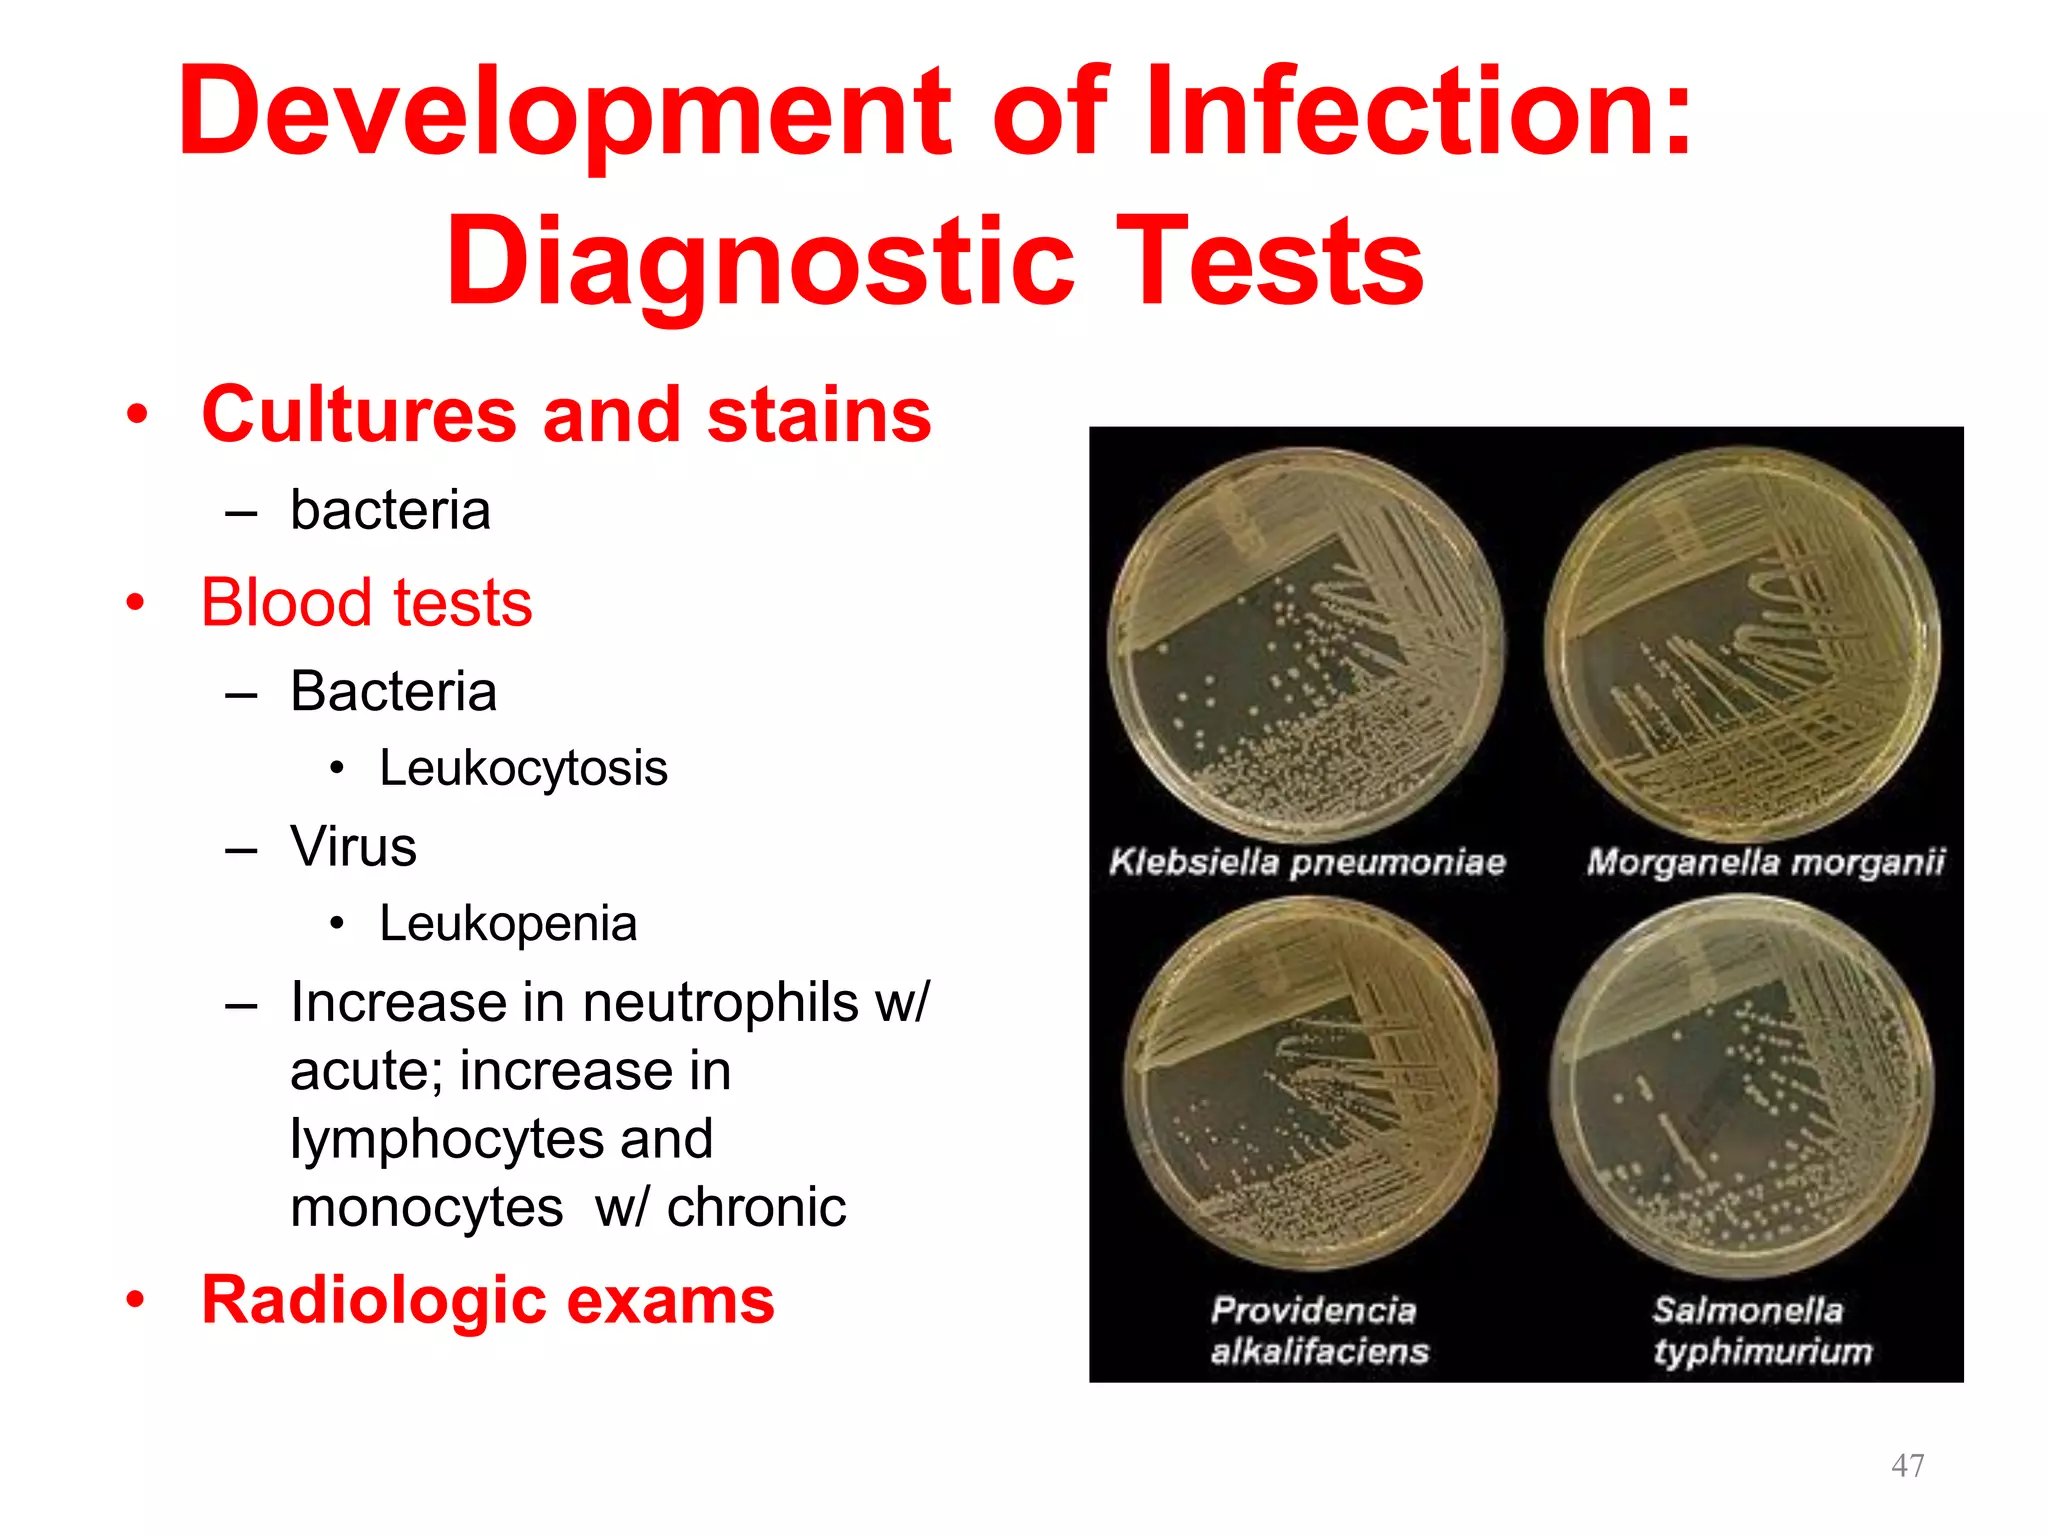
Development of Infection:
Diagnostic Tests
• Cultures and stains
– bacteria
• Blood tests
– Bacteria
• Leukocytosis
– Virus
• Leukopenia
– Increase in neutrophils w/
acute; increase in
lymphocytes and
monocytes w/ chronic
• Radiologic exams
47

This document provides definitions and explanations related to infections. It discusses what constitutes an infection, the types of microorganisms that can cause infections, and how infections are classified. It also describes the normal flora of the human body, how infections develop and spread, methods of diagnosis, and approaches for preventing and treating infections. Key points covered include the difference between acute and chronic infections, the stages of infection including incubation and prodromal periods, and the importance of hygiene, sanitation, and antimicrobial treatments in infection control.





































![Characteristic VIRAL INFECTION BACTERIAL INFECTION
Typical symptoms
SYSTEMIC
This means they involve many different
parts of the body or more than one body
system at the same time; i.e. a runny
nose, sinus congestion, cough, body
aches etc.
They can be local at times as in
viral conjunctivitis or "pink eye" and
herpes.
Only a few viral infections are painful, like
herpes. The pain of viral infections is
often described as itchy or burning.
Localized redness,
heat, swelling and
pain.
One of the hallmarks of a
bacterial infection is local pain,
pain that is in a specific part of
the body.
Bacterial throat pain is often
characterized by more pain on
one side of the throat.
An ear infection is more likely to
be diagnosed as bacterial if the
pain occurs in only one ear.[19]
A cut that produces pus and
milky-colored liquid is most
likely infected.
Cause Pathogenic viruses Pathogenic bacteria](https://image.slidesharecdn.com/infectionintro-210203183937/75/Infection-intro-38-2048.jpg)